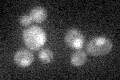
YER038C
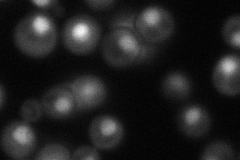
YER038C
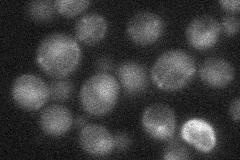
YER038C
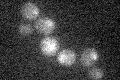
YER038C

View description
Essential subunit of the Mms21-Smc5-Smc6 complex, required for growth and DNA repair; heterozygous mutant shows haploinsufficiency in K1 killer toxin resistance
Localization:
Intensity:
Fold change:
Significance:
-
C’ GFP library in SD
nucleus19.57 -
N' NOP1pr-GFP in SD
nucleus48.9595 -
N' TEF2pr-mCherry in SD

nucleus7.77314 -
N' NATIVEpr-GFP in SD
nucleus25.5524 -
N' TEF2pr-VC and Cyto-VN in SD

below threshold27.2398 -
C’ GFP library in SD+DTT

nucleus22.11.12No -
C’ GFP library in SD+H2O2

nucleus18.590.94No -
C’ GFP library in Starvation Media
nucleus15.770.8No -
C’ GFP library on the background of Pup2-DaMP

nucleus -
C’ GFP library on the background of CCT mutant

nucleus20.20831.03226No
